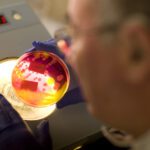
Cormica Microbiology Services plate reading

Bioburden Testing
Bioburden Testing Services – Compliant with BS EN ISO 11737-1
Ensure the Safety and Compliance of Your Medical Devices with Cormica’s Bioburden Testing
Bioburden testing is a critical component in the pre-sterilisation quality control of health care products (medical device, including in vitro diagnostic medical device, or medicinal product, including biopharmaceutical). It involves assessing the population of viable microorganisms present on a product before sterilisation, ensuring that the manufacturing, packaging, and raw material processes meet regulatory standards. Cormica’s bioburden testing services align with BS EN ISO 11737-1, providing manufacturers with reliable data to make informed decisions regarding sterilisation procedures.

Why Choose Cormica for Bioburden Testing?

- BS EN ISO 11737-1 Compliance: Our testing follows BS EN ISO 11737-1 guidelines to verify the viable microbial load on devices, ensuring compliance and meeting regulatory requirements for medical device safety.
- Accurate Detection Methods: Using membrane filtration and other validated recovery methods, we identify and quantify microorganisms such as aerobic bacteria, yeasts, molds and anaerobes.
- Customised Testing Solutions: Our experts develop tailored bioburden testing protocols to meet the unique requirements of each medical device, from small sensors to large, complex systems, as well as pharmaceutical products. Whether testing raw materials, monitoring production lines, or validating cleaning procedures, we adapt our methods to ensure precise and compliant results for both sectors.
- Fast Turnaround Times: We offer expedited testing options to support your project timelines, delivering results quickly to help you meet regulatory and commercial deadlines.
Applications of Bioburden Testing
Bioburden Testing For Medical Devices
Bioburden testing complying with BS EN ISO 11737-1 standards is critical for medical devices, where varied materials and configurations can present contamination risks.
By assessing viable microbial levels, manufacturers can validate their sterilisation protocols, ensuring product safety. Pairing bioburden testing with sterility validation helps maintain regulatory compliance and product integrity throughout the manufacturing process.
Bioburden Testing For Pharmaceutical Products
In pharmaceuticals, pre-sterilisation bioburden testing safeguards the sterility of products such as injectables by monitoring raw materials and in-process controls. This testing is key to meeting stringent quality and regulatory standards.
Combined with endotoxin testing and environmental monitoring, it helps manufacturers minimise contamination risks and ensure product safety across production lines.


Common Microorganisms in Bioburden Testing
Bioburden testing typically identifies a range of microorganisms that may be present on medical devices, pharmaceuticals and other health care products before sterilisation. These microorganisms include:
-
Bacteria:
- Staphylococcus spp. (e.g., Staphylococcus aureus)
- Bacillus spp. (e.g., Bacillus subtilis)
- Pseudomonas spp. (e.g., Pseudomonas aeruginosa)
- Enterobacter spp.
- Streptococcus spp.
-
Fungi:
- Yeasts (e.g., Candida albicans)
- Moulds (e.g., Aspergillus brasiliensis / Aspergillus niger)
-
Spore-forming bacteria:
- Clostridium spp.
- Bacillus cereus
These microorganisms are commonly assessed because they represent potential contaminants that can affect the quality and safety of medical products if not properly managed.
Regulatory Compliance with Bioburden Testing
Bioburden testing must adhere to key standards and regulations to ensure product safety:
- BS EN ISO 11737-1: The primary international standard for determining bioburden levels on medical devices, outlining requirements for validation and control.
- FDA 21 CFR Part 820: Governs bioburden testing as part of Good Manufacturing Practices for medical devices in the US.
- European Pharmacopoeia (EP) & United States Pharmacopeia (USP): Provide guidelines for ensuring the microbiological quality of pharmaceutical products.
These standards help manufacturers maintain compliance and achieve regulatory approval efficiently.
Bioburden Testing FAQ's
Bioburden testing assesses the viable microbial load present on medical devices or pharmaceutical products before sterilisation. It is crucial for ensuring that sterilisation methods are effective and that products meet regulatory standards, minimising the risk of contamination and ensuring patient safety.
The frequency of bioburden testing depends on the type of product and its production environment. For medical devices, testing is typically performed during initial validation, routine monitoring, and whenever there are changes in materials or manufacturing processes to ensure ongoing compliance with ISO 11737-1 and other regulatory requirements.
Common methods include membrane filtration and plate counting techniques. These methods are validated to recover and quantify viable microorganisms efficiently, and they comply with ISO standards. Depending on the product and the specific needs of the manufacturer, Cormica can tailor the testing approach to ensure accurate and reliable results.